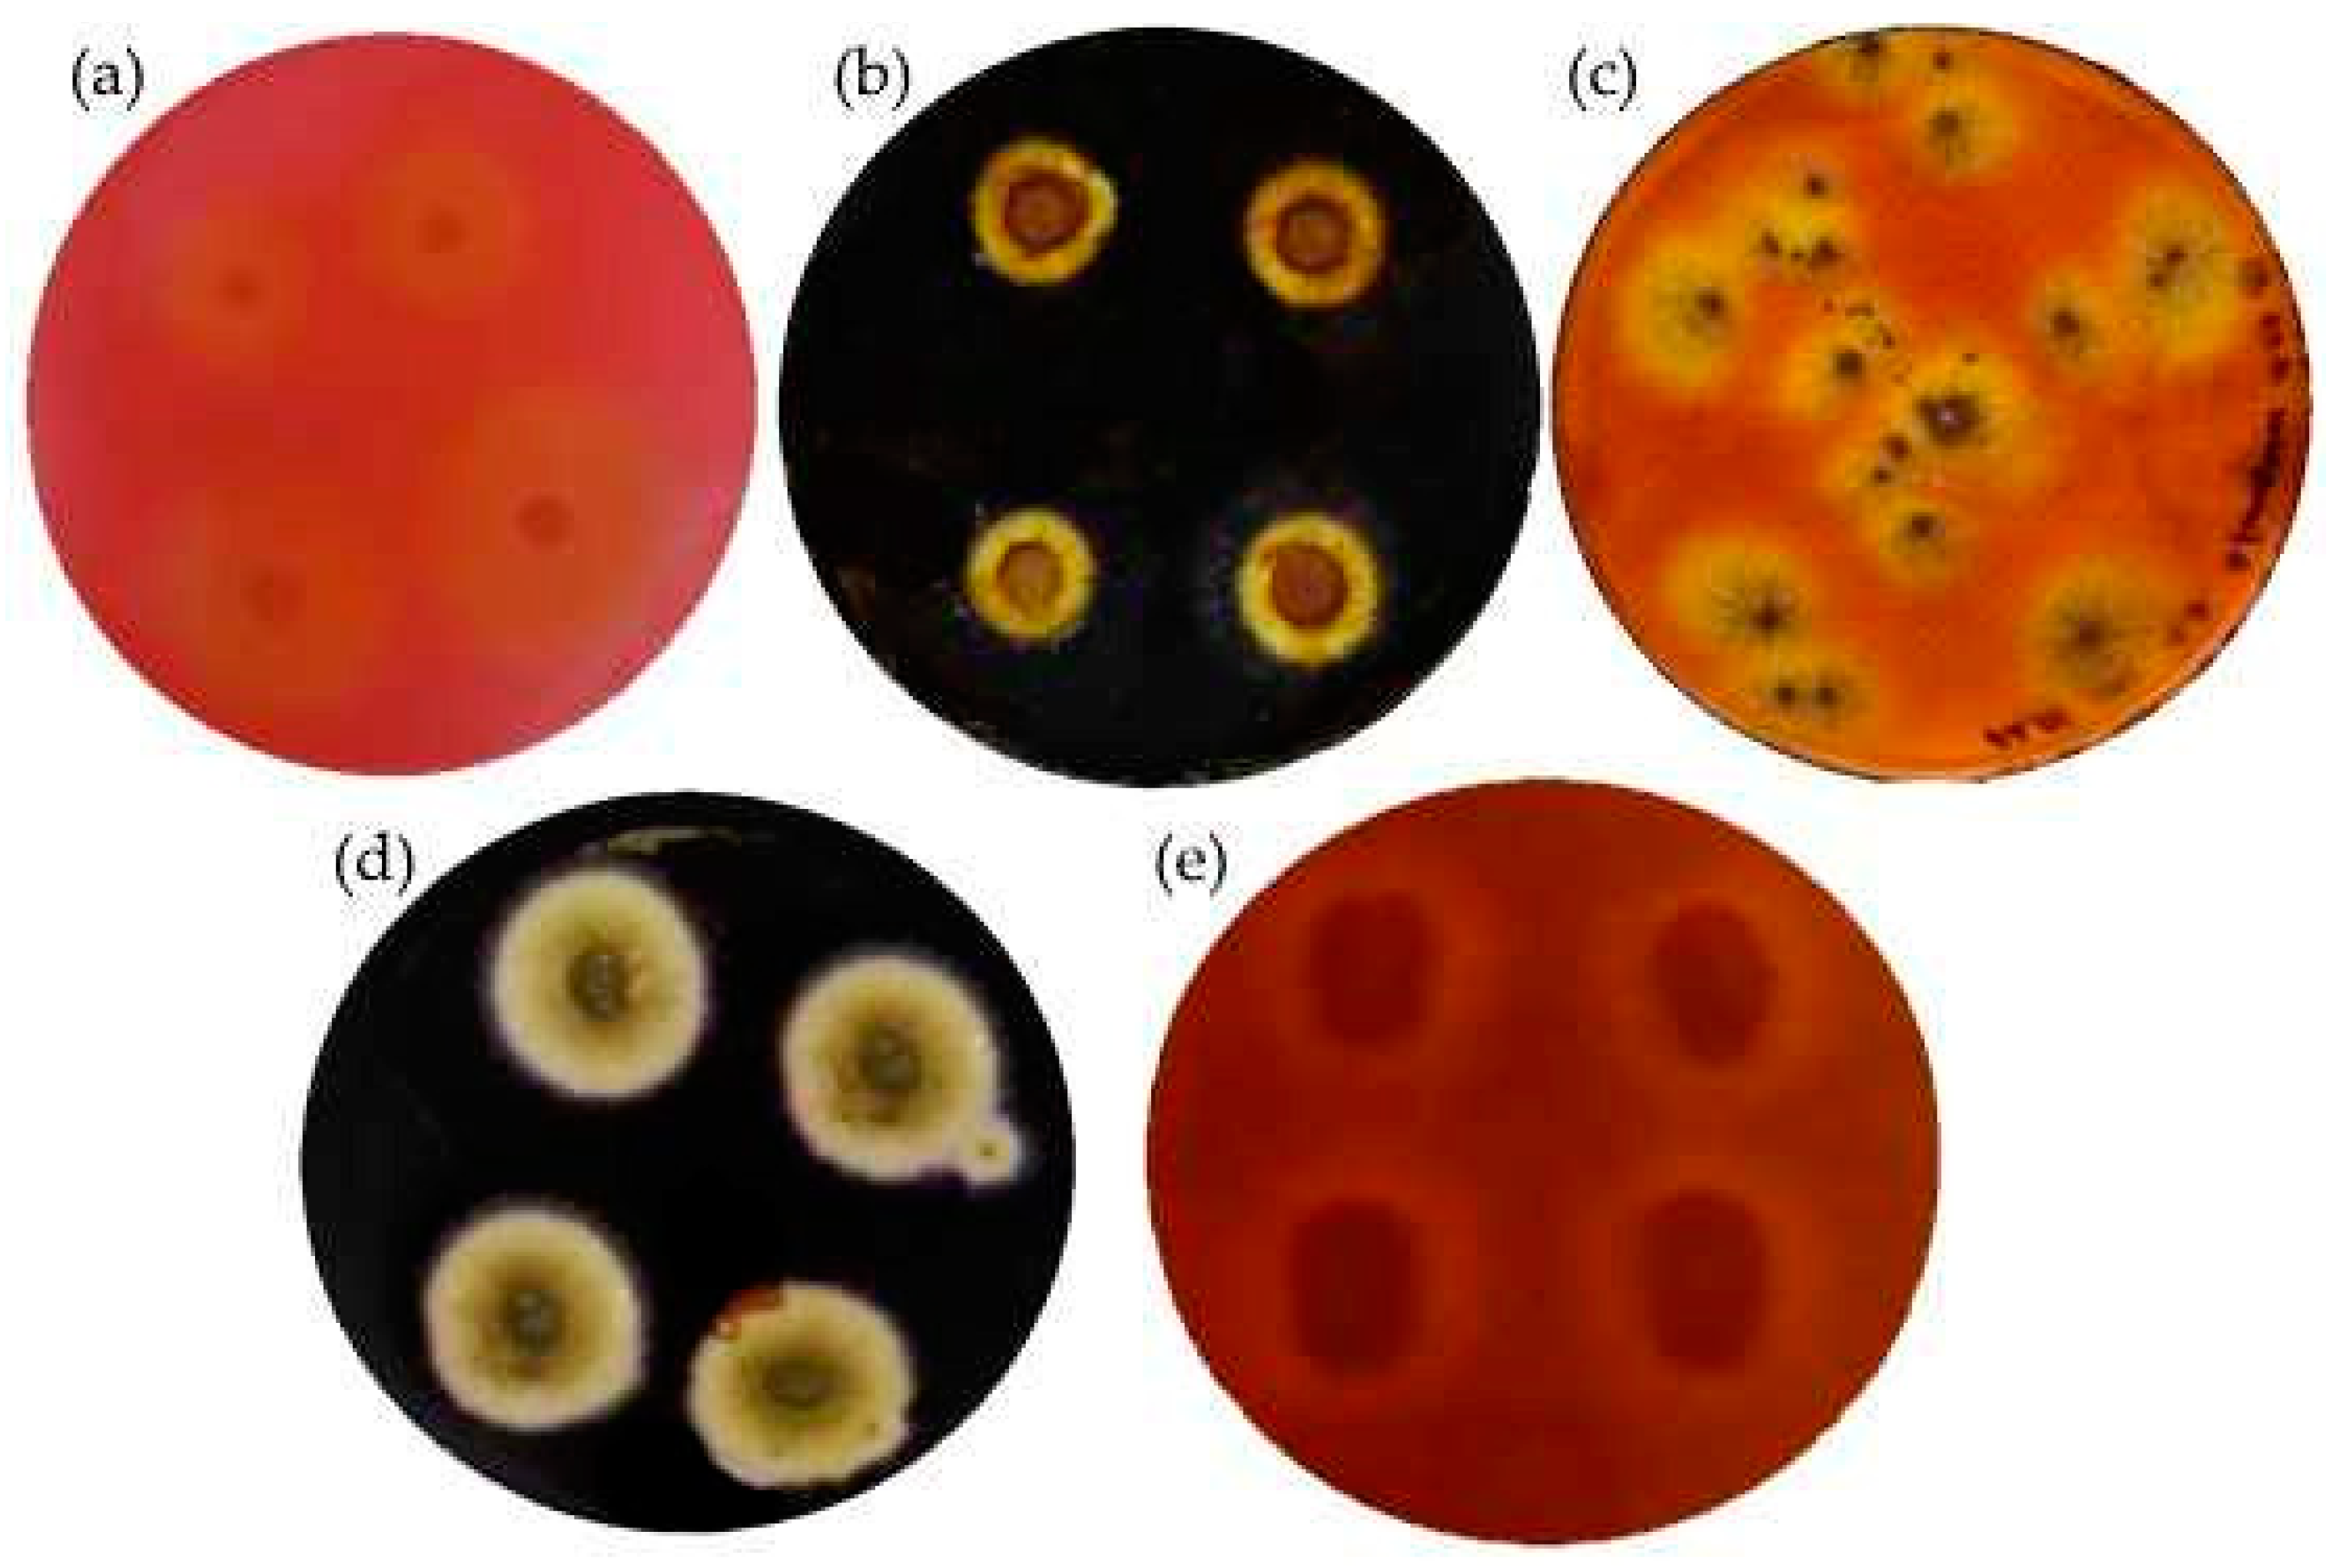
Microorganisms 10 01830 g003

Impact of Cellulolytic Fungi on Biodegradation of Hemp Shives and Corn Starch-Based Composites with Different Flame-Retardants
Abstract
:1. Introduction
2. Materials and Methods
2.1. Raw Materials
2.2. Preparation of BcBs
2.3. Isolation and Identification of Bacterial and Fungal Strains
2.4. Preparation of Microorganisms for Incubation on the BcBs
3. Results and Discussion
3.1. Identification of Bacterial and Fungal Species
3.2. Measurment of Enzymatic Activities
3.3. Microstructure of BcBs after Incubation Period
3.4. Growth of Microorganisms on BcBs
3.5. Mechanical Performance of BcBs after Incubation with the Microorganisms
4. Conclusions
Author Contributions
Funding
Institutional Review Board Statement
Informed Consent Statement
Data Availability Statement
Conflicts of Interest
References
- Lecoublet, M.; Khennache, M.; Leblanc, N.; Ragoubi, M.; Poilâne, C. Physico-mechanical performances of flax fiber biobased composites: Retting and process effect. Ind. Crops Prod. 2021, 173, 114110. [Google Scholar] [CrossRef]
- Andrew, J.J.; Dhakal, H.N. Sustainable biobased composites for advanced applications: Recent trends and future opportunities—A critical review. Compos. Part A Open Access 2022, 7, 100220. [Google Scholar] [CrossRef]
- Lu, M.M.; Fuentes, C.A.; Van Vuure, A.W. Moisture sorption and swelling of flax fibre and flax fibre composites. Compos. Part B Eng. 2022, 231, 109538. [Google Scholar] [CrossRef]
- Rangasamy, G.; Mani, S.; Kolandavelu, S.K.S.; Alsoufi, M.S.; Ibrahim, A.M.M.; Muthusamy, S.; Panchal, H.; Sadasivuni, K.K.; Elsheikh, A.H. An extensive analysis of mechanical, thermal and physical properties of jute fiber composites with different fiber orientations. Case Stud. Therm. Eng. 2021, 28, 101612. [Google Scholar] [CrossRef]
- Mazhoud, B.; Collet, F.; Prétot, S.; Lanos, C. Effect of hemp content and clay stabilization on hygric and thermal properties of hemp-clay composites. Constr. Build. Mater. 2021, 300, 123878. [Google Scholar] [CrossRef]
- Hassan, N.A.A.; Ahmad, S.; Chen, R.S.; Natarajan, V.D. Synergistically enhanced mechanical, combustion and acoustic properties of biopolymer composite foams reinforced with kenaf fibre. Compos. Part A Appl. Sci. Manuf. 2022, 155, 106826. [Google Scholar] [CrossRef]
- Ramamoorthy, S.K.; Skrifvars, M.; Persson, A. A review of natural fibers used in biocomposites: Plant, animal and regenerated cellulose fibers. Polym. Rev. 2015, 55, 107–162. [Google Scholar] [CrossRef]
- Fieldmann, M.; Fuchs, J. Injection Molding of Bio-Based Plastics, Polymers and Composites. In Specialized Injection Molding Techniques, 1st ed.; Elsevier: Amsterdam, The Netherlands, 2015. [Google Scholar]
- Obuka, V.; Sinka, M.; Nikolajeva, V.; Kostjukova, S.; Ozola-Davidane, R.; Klavins, M. Microbiological Stability of Bio-Based Building Materials. J. Ecol. Eng. 2021, 22, 296–313. [Google Scholar] [CrossRef]
- Ray, R.; Das, S.N.; Das, A. Mechanical, thermal, moisture absorption and biodegradation behaviour of date palm leaf reinforced PVA/starch hybrid composites. Mater. Today Proc. 2021, 41, 376–381. [Google Scholar] [CrossRef]
- Ji, M.; Li, F.; Li, J.; Li, J.; Zhang, C.; Sun, K.; Guo, Z. Enhanced mechanical properties, water resistance, thermal stability, and biodegradation of the starch-sisal fibre composites with various fillers. Mater. Des. 2021, 198, 109373. [Google Scholar] [CrossRef]
- Zoungranan, Y.; Lynda, E.; Dobi-Brice, K.K.; Tchirioua, E.; Bakary, C.; Yannick, D.D. Influence of natural factors on the biodegradation of simple and composite bioplastics based on cassava starch and corn starch. J. Environ. Chem. Eng. 2020, 8, 104396. [Google Scholar] [CrossRef]
- Bourdot, A.; Moussa, T.; Gacoin, A.; Maalouf, C.; Vazquez, P.; Thomachot-Schneider, C.; Bliard, C.; Merabtine, A.; Lachi, M.; Douzane, O.; et al. Characterization of a hemp-based agro-material: Influence of starch ratio and hemp shive size on physical, mechanical, and hygrothermal properties. Energy Build. 2017, 153, 501–512. [Google Scholar] [CrossRef]
- Le, A.T.; Gacoin, A.; Li, A.; Mai, T.H.; Rebay, M.; Delmas, Y. Experimental investigation on the mechanical performance of starch-hemp composite materials. Constr. Build. Mater. 2014, 61, 106–113. [Google Scholar] [CrossRef]
- Hussain, A.; Calabria-Holley, J.; Lawrence, M.; Jiang, Y. Hygrothermal and mechanical characterisation of novel hemp shiv based thermal insulation composites. Contr. Build. Mater. 2019, 212, 561–568. [Google Scholar] [CrossRef]
- Kremensas, A.; Vaitkus, S.; Vėjelis, S.; Członka, S.; Kairytė, A. Hemp shivs and corn-starch-based biocomposite boards for furniture industry: Improvement of water resistance and reaction to fire. Ind. Crops Prod. 2021, 166, 113477. [Google Scholar] [CrossRef]
- Haleen Khan, A.A.; Mohan Karuppayil, S. Fungal pollution of indoor environments and its management. Saudi J. Biol. Sci. 2012, 19, 405–426. [Google Scholar] [CrossRef] [PubMed]
- Ghaffarianhoseini, A.; AlWaer, H.; Omrany, H.; Ghaffarianhoseini, A.; Alalouch, C.; Clements-Croome, D.; Tookey, J. Sick building syndrome: Are we doing enough? Archit. Sci. Rev. 2018, 61, 99–121. [Google Scholar] [CrossRef]
- Réquilé, S.; Le Duigou, A.; Bourmaud, A.; Baley, C. Deeper insights into the moisture-induced hygroscopic and mechanical properties of hemp reinforced biocomposites. Compos. Part A Appl. Sci. Manuf. 2019, 123, 278–285. [Google Scholar] [CrossRef]
- Viel, M.; Collet, F.; Lecieux, Y.; François, M.L.M.; Colson, V.; Lanos, C.; Hussain, A.; Lawrence, M. Resistance to mold development assessment of bio-based building materials. Compos. Part B Eng. 2019, 158, 406–418. [Google Scholar] [CrossRef]
- Gupta, V.K.; Kubicek, C.P.; Berrin, J.G.; Wilson, D.W.; Couturier, M.; Berlin, A.; Filho, E.X.F.; Ezeji, T. Fungal Enzymes for Bio-Products from Sustainable and Waste Biomass. Trends Biochem. Sci. 2016, 41, 633–645. [Google Scholar] [CrossRef] [Green Version]
- Ryan, C.A.; Billington, S.L.; Criddle, C.S. Biocomposite fiber-matrix treatments that enhance in-service performance can also accelerate end-of-life fragmentation and anaerobic biodegradation to methane. J. Polym. Environ. 2018, 26, 1715–1726. [Google Scholar] [CrossRef]
- EN 1602; Thermal Insulating Products for Building Applications—Determination of the Apparent Density. European Standardization Committee: Brussels, Belgium, 2013.
- EN 12085; Thermal Insulating Products for Building Applications—Determination of Linear Dimensions of Test Specimens. European Standardization Committee: Brussels, Belgium, 2013.
- EN 826; Thermal Insulating Products for Building Applications—Determination of Compression Behavior. European Standardization Committee: Brussels, Belgium, 2013.
- Ghose, T.K. Measurement of cellulase activities. Pure Appl. Chem. 1987, 59, 257–268. [Google Scholar] [CrossRef]
- Meussen, B.J.; Graaff, L.H.; Sanders, J.P.M.; Weusthuis, R.A. Metabolic engineering of Rhizopus oryzae for the production of platform chemicals. Appl. Microbiol. Biotechnol. 2012, 94, 875–886. [Google Scholar] [CrossRef] [PubMed]
- Karimi, K.; Brandberg, T.; Edebo, L.; Taherzadeh, M.J. Fed-batch cultivation of Mucor indicus in dilute-acid lignocellulosic hydrolyzate for ethanol production. Biotechnol. Lett. 2005, 27, 1395–1400. [Google Scholar] [CrossRef] [PubMed]
- Liu, M.; Ale, M.T.; Kołaczkowski, B.; Fernando, D.; Daniel, G.; Meyer, A.S.; Thygesen, A. Comparison of traditional field retting and Phlebia radiata Cel 26 retting of hemp fibers for fiber-reinforced composites. AMB Express 2017, 7, 58. [Google Scholar] [CrossRef]
- Gohel, H.R.; Contractor, C.N.; Ghosh, S.K.; Braganza, V.J. A comparative study of various staining techniques for determination of extra cellular cellulase activity on Carboxy Methyl Cellulose (CMC) agar plates. Int. J. Curr. Microbiol. Appl. Sci. 2014, 3, 261–266. [Google Scholar]
- Spiridon, I.; Anghel, N.; Bele, A. Behavior of biodegradable composites based on starch reinforced with modified cellulosic fibers. Polym. Adv. Technol. 2015, 26, 1189–1197. [Google Scholar] [CrossRef]
- Rizhikovs, J.; Brazdausks, P.; Dobele, G.; Jurkjane, V.; Paze, A.; Meile, K.; Puke, M. Pretreated hemp shives: Possibilities of conversion into levoglucosan and levoglucosenone. Ind. Crops Prod. 2019, 139, 111520. [Google Scholar] [CrossRef]
- Ji, A.; Jia, L.; Kumar, D.; Yoo, C.G. Recent advancements in biological conversion of industrial hemp for biofuel and value-added products. Fermentation 2021, 7, 6. [Google Scholar] [CrossRef]
- Hidayat, B.J.; Felby, C.; Johansen, K.S.; Thygesen, L.G. Cellulose is not just cellulose: A review of dislocations as reactive sites in the enzymatic hydrolysis of cellulose microfibrils. Cellulose 2012, 19, 1481–1493. [Google Scholar] [CrossRef]
- Gόmez, E.F.; Michel, F.C. Biodegradability of conventional and bio-based plastics and natural fiber composites during composting, anaerobic digestion and long-term soil incubation. Polym. Degrad. Stab. 2013, 98, 2583–2591. [Google Scholar] [CrossRef]
- Hazarika, A.; Mandal, M.; Maji, T.K. Dynamic mechanical analysis, biodegradability and thermal stability of wood polymer nanocomposites. Compos. Part B Eng. 2014, 60, 568–576. [Google Scholar] [CrossRef]
- Barton-Pudlik, J.; Czaja, K.; Grzymek, M.; Lipok, J. Evaluation of wood-polyethylene composites biodegradability caused by filamentous fungi. Int. Bioterror. Biodegr. 2017, 118, 10–18. [Google Scholar] [CrossRef]
- Kremensas, A.; Kairytė, A.; Vaitkus, S.; Vėjelis, S.; Członka, S.; Strąkowska, A. The impact of hot-water-treated fibre hemp shivs on the water resistance and thermal insulating performance of corn starch bonded biocomposite boards. Ind. Crops Prod. 2019, 137, 290–299. [Google Scholar] [CrossRef]
- Gu, J.D.; Lu, C.; Thorp, K.; Crasto, A.; Mitchell, R. Fiber-reinforced polymeric composites are susceptible to microbial degradation. J. Ind. Microbiol. Biotechnol. 1997, 18, 364–369. [Google Scholar] [CrossRef]
- Gu, J.D.; Ford, T.; Thorp, K.; Mitchell, R. Microbial growth on fiber reinforced composite materials. Int. Biodeterior. Biodegrad. 1996, 37, 197–204. [Google Scholar] [CrossRef]
- Altuntas, E.; Yilmaz, E.; Salan, T.; Alma, M.H. Biodegradation properties of wood-plastic composites containing high content of lignocellulosic filler and zinc borate exposed to two different brown-rot fungi. Bioresources 2017, 12, 7161–7177. [Google Scholar]
- Gao, X.; Fan, S.; Pang, J.; Rahman, M.Z.; Zhu, D.; Guo, S.; Ma, M.; Li, Z. Preparation of nano-xylan and its influences on the anti-fungi performance of straw fiber/HDPE composite. Ind. Crops Prod. 2021, 171, 113954. [Google Scholar] [CrossRef]
- Chung, W.-Y.; Wi, S.-G.; Bae, H.-J.; Park, B.-D. Microscopic observation of wood-based composites exposed to fungal deterioration. J. Wood Sci. 1999, 45, 64–68. [Google Scholar] [CrossRef]
- Crawford, B.; Pakpour, S.; Kazemian, N.; Klironomos, J.; Stoeffler, K.; Rho, D.; Denault, J.; Milani, A.S. Effect of fungal deterioration on physical and mechanical properties of hemp and flax natural fiber composites. Materials 2017, 10, 1252. [Google Scholar] [CrossRef]
- Sethi, S.; Dattam, A.; Lal Gupta, B.; Gupta, S. Optimization of cellulase production from bacterial isolated from soil. Int. Sch. Res. Notices 2013, 2013, 1–7. [Google Scholar]
- Poly, N.Y.; Mamtaz, S.; Khan, M.M.H.; Hoque, M.N.; Azad, A.K.; Hasan, M. Isolation, documentation, and biochemical characterization of cellulolytic bacteria from rumen fluid of cattle. Int. J. Adv. Biotechnol. Res. 2022, 5, 433–444. [Google Scholar] [CrossRef]
- Moller, E.B.; Andersen, B.; Rode, C.; Peuhkuri, R. Conditions for mould growth on typical interior surfaces. Energy Procedia 2017, 132, 171–176. [Google Scholar] [CrossRef]
- Hung, W.-C.; Wu, K.-H.; Lyu, D.-Y.; Cheng, K.-F.; Huang, W.-C. Preparation and characterization of expanded graphite/metal oxides for antimicrobial application. Mater. Sci. Eng. 2017, 75, 1019–1025. [Google Scholar] [CrossRef]
- Liu, S.; Zeng, T.H.; Hofmann, M.; Burcombe, E.; Wei, J.; Jiang, R.; Kong, J.; Chen, Y. Antibacterial activity of graphite, graphite oxide, graphene oxide, and reduced graphene oxide: Membrane and oxidative stress. ACS Nano 2011, 5, 6971–6980. [Google Scholar] [CrossRef]
- Hamzeh, Y.; Ashori, A.; Marvast, H.E.; Rashedi, K.; Olfat, A.M. A comparative study on the effects of Coriolus versicolor on properties of HDPE/wood flour/paper sludge composites. Compos. Part B Eng. 2012, 43, 2409–2414. [Google Scholar] [CrossRef]
- Kord, B.; Ayrilmis, N.; Ghalehno, M.D. Effect of fungal degradation on technological properties of carbon nanotubes reinforced polypropylene/rice straw composites. Polym. Polym. Compos. 2020, 29, 303–310. [Google Scholar] [CrossRef]

| Raw Material | Composition | ||
|---|---|---|---|
| Control | G | F | |
| HS, g | 300 | 300 | 300 |
| CS, g | 30 | 30 | 30 |
| Boiling water, L | 2 | 2 | 2 |
| G, wt.% | 0 | 10 | 0 |
| F, g/L | 0 | 0 | 30 |
Publisher’s Note: MDPI stays neutral with regard to jurisdictional claims in published maps and institutional affiliations. |
© 2022 by the authors. Licensee MDPI, Basel, Switzerland. This article is an open access article distributed under the terms and conditions of the Creative Commons Attribution (CC BY) license (https://creativecommons.org/licenses/by/4.0/).
Share and Cite
Vasiliauskienė, D.; Boris, R.; Balčiūnas, G.; Kairytė, A.; Urbonavičius, J. Impact of Cellulolytic Fungi on Biodegradation of Hemp Shives and Corn Starch-Based Composites with Different Flame-Retardants. Microorganisms 2022, 10, 1830. https://doi.org/10.3390/microorganisms10091830
Vasiliauskienė D, Boris R, Balčiūnas G, Kairytė A, Urbonavičius J. Impact of Cellulolytic Fungi on Biodegradation of Hemp Shives and Corn Starch-Based Composites with Different Flame-Retardants. Microorganisms. 2022; 10(9):1830. https://doi.org/10.3390/microorganisms10091830
Chicago/Turabian StyleVasiliauskienė, Dovilė, Renata Boris, Giedrius Balčiūnas, Agnė Kairytė, and Jaunius Urbonavičius. 2022. "Impact of Cellulolytic Fungi on Biodegradation of Hemp Shives and Corn Starch-Based Composites with Different Flame-Retardants" Microorganisms 10, no. 9: 1830. https://doi.org/10.3390/microorganisms10091830
APA StyleVasiliauskienė, D., Boris, R., Balčiūnas, G., Kairytė, A., & Urbonavičius, J. (2022). Impact of Cellulolytic Fungi on Biodegradation of Hemp Shives and Corn Starch-Based Composites with Different Flame-Retardants. Microorganisms, 10(9), 1830. https://doi.org/10.3390/microorganisms10091830

